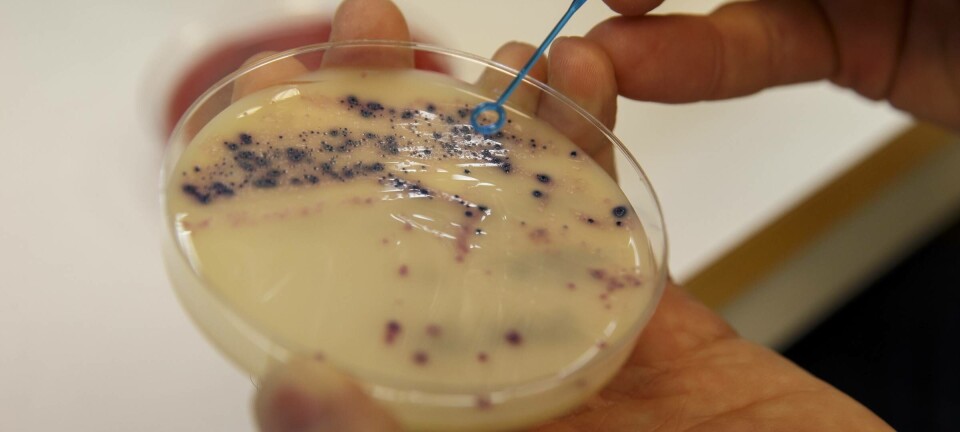

Partner articles from:

Oslo Metropolitan University (Oslomet) is a public university with campuses in Oslo, Sandvika and Kjeller. Oslomet conducts research and offers programmes of professional study in nursing, teacher education, pre-kindergarten education, social work, engineering, journalism, design studies and business administration. Read more at Oslomet. The articles are financed by Oslomet and written by their communication staff - read more about partner articles at ScienceNorway.